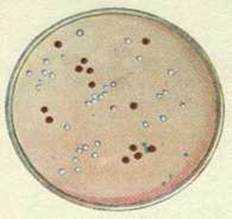
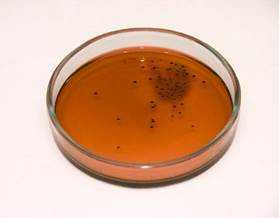
http://spravka.ua/thumbnail.php?size=700&path=http://spravka.ua/company/pphoto/8c/8cd/8cde574140cdf253a6a0bdf6566a6b7a.jpg&fid=289653&md=779d5be3d560dc995b8bc9c489f6c48d

Влияние окружающей среды на рост бактерий.
Добавил пользователь Дмитрий К. Обновлено: 23.10.2025
Существует определенный параллелизм между жизнедеятельностью микроорганизмов и факторами окружающей среды. Чем благоприятнее эти условия для данного микроорганизма, тем интенсивнее он развивается и тем выше темп его жизнедеятельности. Связь микроорганизмов с окружающей средой проявляется в течение всего периода индивидуального развития, причем она имеет многосторонний характер. При ассимиляции питательных веществ микроорганизм растет, развивается и выделяет в окружающую среду определенные продукты обмена. На изменение условий питания он отвечает приспособительной перестройкой своего обмена веществ. При изменении реакции среды, температуры, концентрации питательных веществ, давления, радиации и т. д. нарушается обмен веществ, прекращаются или ограничиваются рост и размножение микроорганизма. Иными словами, происходят все те морфологические и физиологические изменения, которые объединяются в понятие жизнедеятельность.
Обмен веществ у микроорганизмов не сводится только к построению веществ тела, к размножению. Одновременно осуществляются различные процессы, приводящие к улучшению самими микроорганизмами условий внешней среды для дальнейшего размножения. Естественно, ни влажность, ни температура не зависят от микроорганизма. К ним он может только пассивно приспосабливаться. Микроорганизмы могут приспосабливаться к своим потребностям и активно изменять при помощи ферментных систем химические условия. Например подщелачивание среды автоматически активирует ферменты, способные вызывать кислотообразование, интенсивная аэрация вызывает образование защитных восстановительных соединений, снижающих окислительно-восстановительный потенциал rH2.
Все факторы внешней среды, оказывающие большое влияние на развитие микроорганизмов, можно разделить на три основные группы: физические, химические и биологические. Из физических факторов наиболее важное значение имеют влажность, концентрация веществ, температура, радиация, свет; из химических - реакция среды и окислительно-восстановительные условия в ней; из биологических - антимикробные вещества. Необходимо помнить, что существует тесная взаимосвязь между многими факторами окружающей среды и что изменение одного из них часто меняет реакцию микроорганизма на действие других факторов.
Физические факторы
Влажность. В клетках микроорганизмов протекает множество различных биохимических процессов. Одни сложные вещества разлагаются, другие образуются из более простых соединений. Вода же является той необходимой средой, в которой только и могут осуществляться все эти химические реакции. Микробная клетка на 65-85 % состоит из воды, и вся ее жизнедеятельность связана с наличием влаги (табл. 1.1).

Без предварительного растворения в воде многие питательные вещества не могут проникнуть внутрь микробной клетки, и жизнь ее становится невозможной. Большое влияние оказывает наличие влаги на микробные клетки, находящиеся в стадии роста, хотя между ними и в этом отношении наблюдаются значительные различия. Микроскопические грибы могут расти и на твердых питательных субстратах с минимальным содержанием воды. Микроорганизмы в природе находятся в непрерывно изменяющихся условиях, сильно колеблется и содержание влаги. Многие представители хорошо приспособились к высушиванию. Например, некоторые бесспоровые бактерии переносят высушивание и остаются жизнеспособными иногда в течение нескольких лет. Особенно хорошо приспособились к высушиванию споры различных грибов и бактерий. Споры, находящиеся в течение многих лет в сухом месте, при увлажнении начинают прорастать. Однако, как бы стойки ни были вегетативные клетки микроорганизмов к высушиванию, в высушенном состоянии они остаются бездеятельными, так как отсутствие влаги препятствует процессам их питания, а следовательно, росту и размножению. В этом состоянии, что особенно важно, они только сохраняются, хотя их жизнедеятельность заметно приостанавливается.
Концентрация веществ. На рост и жизнедеятельность микроорганизмов большое влияние оказывает концентрация различных веществ. Высокие концентрации любых веществ, в том числе питательных, создают высокое осмотическое давление во внешней среде, превышающее внутреннее осмотическое давление в клетке. Вода при этом выходит наружу, клетки обезвоживаются и начинается плазмолиз. Из-за невозможности поступления в микробную клетку питательных веществ прекращается нормальный обмен с внешней средой. Благодаря тому что цитоплазматическая мембрана имеет высокую избирательную проницаемость, клетки приспосабливаются к изменению осмотического давления в окружающей среде. В этих условиях может иметь место даже накопление в цитоплазме или минеральных солей (если они могут проникать в клетку), или осмотически активных веществ, образующихся в результате гидролиза резервных веществ цитоплазмы.
В последнем случае можно говорить даже об определенной способности к осморегуляции.

Концентрация питательного вещества должна быть оптимальной, т. е. достаточной для обеспечения максимального роста. Для различных веществ оптимальные концентрации различны. Так, минеральные соли, содержащие Р, S, Са, Mg, Zn, Na и другие элементы, требуются в небольших количествах. Концентрации минеральных солей, необходимые для нормального роста различных микроорганизмов, приведены в табл. 1.2. Концентрация в среде источников углерода (углеводы, кислоты, спирты, углеводороды и др.), которые чаще всего одновременно являются и источниками энергии, т. е. окисляемыми или сбраживаемыми веществами, может изменяться от десятых долей процента до 15-20%. Абсолютное содержание источника углерода для обеспечения нормальной жизнедеятельности микроорганизма и получения необходимого количества метаболита рассчитывают, используя экспериментально установленные экономические коэффициенты выхода.
Температура. Жизнь и размножение микроорганизмов зависят от многих физических факторов. Наиболее существенным фактором является прежде всего температура окружающей среды. Как и все факторы внешней среды, температурная зависимость характеризуется тремя кардинальными точками (минимум, оптимум, максимум), которые различны для отдельных микроорганизмов (табл. 1.3). Все микроорганизмы по их отношению к температуре делят на три основные группы: психрофилы, мезофилы и термофилы (рис. 1.6).
Температурный оптимум психрофилов находится в пределах 0-15 °С. Сюда относятся преимущественно представители микрофлоры северных морей. Для психрофилов характерна небольшая скорость роста. Ко второй группе относится большинство используемых в промышленности бактериальных и грибных культур микроорганизмов, температурный оптимум развития которых находится в пределах 25-37 °С. К термофильным микроорганизмам относятся формы, температурный оптимум которых 50-60 °С, крайние пределы 30-70 °С. Термофильные микроорганизмы представляют особый интерес для промышленного использования, так как культивирование их при высоких температурах создает селективные условия и позволяет снизить требования к стерильности процесса.
Свет. На развитие микроорганизмов большое влияние оказывают солнечный свет и другие формы лучистой энергии. Наиболее сильным действием обладает коротковолновая ультрафиолетовая часть спектра (200-300 нм) с ярко выраженным фотохимическим эффектом. Большой активностью обладают также рентгеновские лучи (ионизирующее излучение с длиной волны 0,005-1 нм), y-лучи (коротковолновые рентгеновские лучи), а-, B-частицы, нейтроны. Действие всех этих форм лучистой энергии на микроорганизмы зависит от дозы, а также от физиолого-биохимического состояния микроорганизма. Есть все основания полагать, что действие различного рода излучений связано в первую очередь с изменением структуры ДНК. Во многих случаях спектр действия УФ-лучей соответствует спектру их поглощения нуклеиновыми кислотами. При изучении механизма действия УФ-лучей на молекулярном уровне было обнаружено, что при денатурации ДНК, облученной высокими дозами УФ-лучей (порядка 1*10-2 Дж), возникают разрывы между нуклеотидами, а также образование поперечных сшивок между комплементарными нитями молекулы ДНК.
Действие рентгеновских лучей также связано с ДНК. Наблюдения показали, что рентгеновские лучи, а также некоторые продукты, возникающие под их действием (Н+ и ОН-, радикалы, перекиси), разрушают ДНК.
Следует отметить, что на влиянии различного рода излучений на микроорганизмы основаны приемы стерилизации воды и некоторых других продуктов.
Давление. Микроорганизмы устойчивы к давлению в 500 и даже 1000 кПа, что, по-видимому, связано с малой чувствительностью белков к его денатурирующему влиянию. Для большинства микроорганизмов давление 100 МПа приводит к летальному исходу.
Химические факторы
Концентрация ионов водорода. Большое влияние на развитие микроорганизмов оказывает такой химический фактор внешней среды, как концентрация ионов водорода или pH. Каждый микроорганизм имеет свой максимум и минимум pH, в пределах которых он может развиваться (табл. 1.4).

Как свидетельствуют данные таблицы, есть и некоторые общие закономерности. Бактериальные микроорганизмы хорошо развиваются при pH, близком к нейтральному - от 6,5 до 7,5. У микроскопических грибов и различных видов дрожжей оптимум pH в кислой зоне - от 4 до 6. Концентрация водородных ионов в среде оказывает большое влияние на развитие микроорганизмов и на их физиологическую активность. Это положение можно подтвердить ходом процесса брожения. Например, при спиртовом брожении, протекающем при pH 4, образуются диоксид углерода и этиловый спирт. При сдвиге pH в щелочную сторону (до 7,5) брожение также происходит, но в этом случае кроме диоксида углерода и спирта образуется еще и уксусная кислота.
Окислительно-восстановительный потенциал. Выражают через rH2. Если pH выражает степень кислотности и щелочности, то rH2 - степень аэробности. И. Л. Работнова (1958) показала, что в водном растворе, насыщенном кислородом, rH2 = 41, а в условиях насыщения водородом - rH2 = 0. Шкала от 0 до 41 характеризует любую степень аэробности. По отношению к этому фактору внешней среды все микроорганизмы подразделяются на следующие основные группы: аэробы, анаэробы и факультативные анаэробы. Аэробы содержат в своих клетках систему дыхательных ферментов и в качестве акцепторов водорода при окислительно-восстановительных процессах используют молекулярный кислород. Для аэробных микроорганизмов, например для дрожжей, rH2= 10 / 30 (рис. 1.7, а). Анаэробы получают энергию без участия кислорода воздуха за счет сопряженного окисления - восстановления веществ субстрата. Эти микроорганизмы жизнедеятельны при rH2 не выше 20. Рис. 1.7, б свидетельствует, что размножаются анаэробы только при крайне низких значениях rH2 - не выше 3-5. Для представителей этой группы микроорганизмов молекулярный кислород не только не нужен, но в ряде случаев и ядовит.

Микроорганизмы, для которых кислород не обязателен, так как они живут за счет сопряженного окисления-восстановления без вовлечения кислорода, называются факультативными анаэробами. Они живут в широком диапазоне rH2 - от 0 до 30. Кислород для них не ядовит или слабо ядовит.
Биологические факторы (антимикробные вещества)
Различные вещества, находящиеся в окружающей среде, могут служить источником питания микроорганизмов и способствовать росту и развитию, а могут и ингибировать рост микробной клетки, не оказывая на нее летального действия. Наиболее известными антимикробными веществами являются антибиотики, которые даже в небольших концентрациях угнетают рост и активность микробов. Антибиотики образуют главным образом актиномицеты, а также некоторые грибы и бактерии. Механизм действия антибиотиков состоит в том, что одни из них нарушают процессы деления бактериальной клетки, другие изменяют отдельные процессы метаболизма, мешают использованию витаминов, конкурируют с отдельными ферментами, нарушают процессы дыхания, способствуют образованию перекисей, лизису клеток, оказывают депрессирующее действие на поверхностное натяжение и т. д.
Влияние факторов внешней среды на микроорганизмы
Изменение условий внешней среды оказывает воздействие на жизнедеятельность микроорганизмов. Физические, химические, биологические факторы среды могут ускорять или подавлять развитие микробов, могут изменять их свойства или даже вызывать гибель.
К факторам среды, оказывающим наиболее заметное действие на микроорганизмы, относятся влажность, температура, кислотность и химический состав среды, действие света и других физических факторов.
Влажность. Микроорганизмы могут жить и развиваться только в среде с определенным содержанием влаги. Вода необходима для всех процессов обмена веществ микроорганизмов, для нормального осмотического давлении в микробной клетке, для сохранения ее жизнеспособности. У различных микроорганизмов потребность в воде не одинакова. Бактерии относятся в основном к влаголюбивым, при влажности среды ниже 20 % их рост прекращается. Для плесеней нижний предел влажности среды составляет 15 %, а при значительной влажности воздуха и ниже.
Оседание водяных паров из воздуха на поверхность продукта способствует размножению микроорганизмов. При снижении содержания воды в среде рост микроорганизмов замедляется и может совсем прекращаться. Поэтому сухие продукты могут храниться значительно дольше продуктов с высокой влажностью. Сушка продуктов позволяет сохранять продукты при комнатной температуре без охлаждения.
Некоторые микробы очень устойчивы к высушиванию, некоторые бактерии и дрожжи в высушенном состоянии могут сохраняться до месяца и более. Споры бактерий и плесневых грибов сохраняют жизнеспособность при отсутствии влаги десятки, а иногда и сотни лет.
Температура. Температура — важнейший фактор для развития микроорганизмов. Для каждого из микроорганизмов существует минимум, оптимум и максимум температурного режима для роста. По этому свойству микробы подразделяются на три группы:
• психрофилы — микроорганизмы, хорошо растущие при низких температурах с минимумом при -10—0 о С, оптимумом при 10-15 о С;
• мезофилы — микроорганизмы, для которых оптимум роста наблюдается при 25—35 о С, минимум — при 5—10 о С, максимум — при 50-60 °С;
• термофилы — микроорганизмы, хорошо растущие при относительно высоких температурах с оптимумом роста при 50-65 °С, максимумом — при температуре более 70 о С.
Большинство микроорганизмов относится к мезофилам, для развития которых оптимальной является температура 25-35 °С. Поэтому хранение пищевых продуктов при такой температуре приводит к быстрому размножению в них микроорганизмов и порче продуктов. Некоторые микробы при значительном накоплении в продуктах способны привести к пищевым отравлениям человека. Патогенные микроорганизмы, т.е. вызывающие инфекционные заболевания человека, также относятся к мезофилам.
Низкие температуры замедляют рост микроорганизмов, но не убивают их. В охлажденных пищевых продуктах роет микроорганизмов замедленно, но продолжается. При температуре ниже О о С большинство микробов прекращают размножаться, т.е. при замораживании продуктов рост микробов останавливается, некоторые из них постепенно отмирают. Установлено, что при температуре ниже О о С большинство микроорганизмов впадают в состояние, похожее на анабиоз, сохраняют свою жизнеспособность и при повышении температуры продолжают свое развитие. Это свойство микроорганизмов следует учитывать при хранении и дальнейшей кулинарной обработке пищевых продуктов. Например, в замороженном мясе могут длительно сохраняться сальмонеллы, а после размораживания мяса они в благоприятных условиях быстро накапливаются до опасного для человека количества.
При воздействии высокой температуры, превышающей максимум выносливости микроорганизмов, происходит их отмирание. Бактерии, не обладающие способностью образовывать споры, погибают при нагревании во влажной среде до 60-70 °С через 15-30 мин, до 80—100 о С — через несколько секунд или минут. У спор бактерий термоустойчивость значительно выше. Они способны выдерживать 100 °С в течение 1—6 ч, при температуре 120—130 °С споры бактерий во влажной среде погибают через 20—30 мин. Споры плесеней менее термостойки.
Тепловая кулинарная обработка пищевых продуктов в общественном питании, пастеризация и стерилизация продуктов в пищевой промышленности приводят к частичной или полной (стерилизация) гибели вегетативных клеток микроорганизмов.
При пастеризации пищевой продукт подвергается минимальному температурному воздействию. В зависимости от температурного режима различают низкую и высокую пастеризацию.
Низкая пастеризация проводится при температуре, не превышающей 65—80 о С, не менее 20 мин для большей гарантии безопасности продукта.
Высокая пастеризация представляет собой кратковременное (не более 1 мин) воздействие на пастеризуемый продукт температуры выше 90 °С, которая приводит к гибели патогенной неспороносной микрофлоры и в то же время не влечет за собой существенных изменений природных свойств пастеризуемых продуктов. Пастеризованные продукты не могут храниться без холода.
Стерилизация предусматривает освобождение продукта от всех форм микроорганизмов, в том числе и спор. Стерилизация баночных консервов проводится в специальных устройствах — автоклавах (под давлением пара) при температуре 110—125 о С в течение 20—60 мин. Стерилизация обеспечивает возможность длительного хранения консервов. Молоко стерилизуется методом ультравысокотемпературной обработки (при температуре выше 130 °С) в течение нескольких секунд, что позволяет сохранить все полезные свойства молока.
Реакция среды. Жизнедеятельность микроорганизмов зависит от концентрации водородных (Н') или гидроксильных (ОН~) ионов в субстрате, на котором они развиваются. Для большинства бактерий наиболее благоприятна нейтральная (рН около 7) или слабощелочная среда. Плесневые грибы и дрожжи хорошо растут при слабокислой реакции среды. Высокая кислотность среды (рН ниже 4,0) препятствует развитию бактерий, однако плесени могут продолжать расти и в более кислой среде. Подавление роста гнилостных микроорганизмов при подкислении среды имеет практическое применение. Добавление уксусной кислоты используется при мариновании продуктов, что препятствует процессам гниения и позволяет сохранить продукты.
Образующаяся при квашении молочная кислота также подавляет рост гнилостных бактерий.
Концентрация соли и сахара. Поваренная соль и сахар издавна используются для повышения стойкости продуктов к микробной порче и лучшей сохранности пищевых продуктов. Повышение содержания растворенных веществ (соли или сахара) в питательной среде сказывается на величине осмотического давления внутри микроорганизмов, вызывает их обезвоживание. При повышении концентрации поваренной соли в субстрате более 3—4 % размножение многих, в том числе гнилостных, микроорганизмов замедляется, при концентрации более 7—12% прекращается.
Некоторые микроорганизмы нуждаются для своего развития в высоких концентрациях соли (20 % и выше). Их называют солелюбивыми, или галофилами. Они могут вызывать порчу соленых продуктов.
Высокие концентрации сахара (выше 55—65 %) прекращают размножение большинства микроорганизмов, это используетея при приготовлении из плодов и ягод варенья, джема или повидла. Однако эти продукты тоже могут подвергаться порче в результате размножения осмофильных плесеней или дрожжей.
Свет. Некоторым микроорганизмам свет необходим для нормального развития, но для большинства из них он губителен. Ультрафиолетовые лучи солнца обладают бактерицидным действием, т. е. при определенных дозах облучения приводят к гибели микроорганизмов. Бактерицидные свойства ультрафиолетовых лучей ртутно-кварцевых ламп используют для дезинфекции воздуха, воды, некоторых пищевых продуктов. Инфракрасные лучи тоже могут вызвать гибель микробов за счет теплового воздействия. Воздействие этих лучей применяют при тепловой обработке продуктов. Негативное воздействие на микроорганизмы могут оказывать электромагнитные поля, ионизирующие излучения и другие физические факторы среды.
Химические факторы. Некоторые химические вещества способны оказывать на микроорганизмы губительное действие. Химические вещества, обладающие бактерицидным действием, называют антисептиками. К ним относятся дезинфицирующие средства (хлорная известь, гипохлориты и др.), используемые в медицине, на предприятиях пищевой промышленности и общественного питания.
Некоторые антисептики применяются в качестве пищевых добавок (сорбиновая и бензойная кислоты и др.) при изготовлении соков, икры, кремов, салатов и других продуктов.
Биологические факторы. Между различными микроорганизмами могут устанавливаться разные взаимоотношения: симбиоз — взаимовыгодные отношения; метабиоз — жизнедеятельность одного за счет другого без принесения вреда; паразитизм — жизнедеятельность одного за счет другого с причинением ему вреда; антагонизм — один из видов микроорганизмов угнетает развитие другого,
что может привести к гибели микробов. Например, развитие молочнокислых бактерий угнетает рост гнилостных, эти антагонистические взаимоотношения используют при квашении овощей или для поддержания нормальной микрофлоры в кишечнике человека.
Антагонистические свойства некоторых микроорганизмов объясняются способностью их выделять в окружающую среду вещества, обладающие антимикробным (бактериостатическим, бактерицидным или фунгицидным) действием, — антибиотики.
Антибиотики продуцируются в основном грибами, реже бактериями, они оказывают свое специфическое действие на определенные виды бактерий или грибов (фунгицидное действие). Антибиотики применяются в медицине (пенициллин, левомицетин, стрептомицин и др.), в животноводстве в качестве кормовой добавки, в пищевой промышленности для консервирования пищевых продуктов (низин).
Антибиотическими свойствами обладают фитонциды — вещества, обнаруженные во многих растениях и пищевых продуктах (лук, чеснок, редька, хрен, пряности и др.). К фитонцидам относятся эфирные масла, антоцианы и другие вещества. Они способны вызывать гибель патогенных микроорганизмов и гнилостных бактерий.
В яичном белке, рыбной икре, слезах, слюне содержится лизоцим — антибиотическое вещество животного происхождения.
1. Значение влажности среды для жизнедеятельности микробов.
2. Влияние температуры среды на жизнедеятельность микроорганизмов.
3. Какие микроорганизмы называют психрофилами, мезофилами и термофилами?
4. Значение рН среды для жизнедеятельности микробов.
5. Влияние концентрации соли и сахара на жизнедеятельность микробов.
6. Каково воздействие света на микроорганизмы?
7. Как влияют на микроорганизмы антисептики, антибиотики и другие вещества?
Влияние факторов внешней среды на рост и размножение микроорганизмов.
Жизнедеятельность микроорганизмов находится в зависимости от факторов окружающей среды, которые могут оказывать бактерицидное, т.е. уничтожающее, действие на клетки или бактериостатическое, подавляющее размножение микроорганизмов. Мутагенное действие приводит к изменению наследственных свойств. Физические, химические и биологические факторы окружающей среды оказывают различное воздействие на микроорганизмы.
Влияние физических факторов. Различные группы микроорганизмов развиваются при определенных диапазонах температур. Бактерии, растущие при низкой температуре, называют психрофилами, при средней (около 37 °С) - мезофилами, при высокой - термофилами.
К психрофильным микроорганизмам относится большая группа сапрофитов - обитателей почвы, морей, пресных водоемов и сточных вод (железобактерии, псевдомонады, светящиеся бактерии, бациллы). Некоторые из них могут вызывать порчу продуктов питания на холоде. Способностью расти при низких температурах обладают и некоторые патогенные бактерии (возбудитель псевдотуберкулеза размножается при температуре 4°С). В зависимости от температуры культивирования свойства бактерий меняются. Так, Serratia marcescens образуют при температуре 20-25°С большее количество красного пигмента (продигиозана), чем при температуре 37°С. Синтез полисахаридов, в том числе капсульных, активируется при более низких температурах культивирования. Интервал температур, при котором возможен рост психрофильных бактерий, колеблется от -10 до 40°С, а температурный оптимум от 15 до 40°С, приближаясь к температурному оптимуму мезофильных бактерий. Мезофилы включают основную группу патогенных и условно-патогенных бактерий. Они растут в диапазоне температур 10 - 47°С; оптимум роста для большинства из них 37°С. При более высоких температурах (от 40 до 90°С) развиваются термофильные бактерии. На дне океана в горячих сульфидных водах живут бактерии, развивающиеся при температуре 250-300°С и давлении 262 атм. Термофилы обитают в горячих источниках, участвуют в процессах самонагревания навоза, зерна, сена. Наличие большого количества термофилов в почве свидетельствует о ее загрязненности навозом и компостом. Поскольку навоз наиболее богат термофилами, их рассматривают как показатель загрязненности почвы.
Температурный фактор учитывают при проведении стерилизации. Вегетативные формы бактерий погибают при температуре 60°С в течение 20-30 мин; споры погибают в автоклаве при 120°С под давлением пара. Хорошо выдерживают микроорганизмы действие низких температур. Поэтому их можно долго хранить в замороженном состоянии, в том числе при температуре жидкого газа (≈173°С).
Высушивание. Обезвоживание вызывает нарушение функций большинства микроорганизмов. Наиболее чувствительны к высушиванию патогенные микроорганизмы (возбудители гонореи, менингита, холеры, брюшного тифа, дизентерии и др.). Более устойчивыми являются микроорганизмы, защищенные слизью мокроты. Так, бактерии туберкулеза в мокроте выдерживают высушивание до 90 дней. Устойчивы к высушиванию некоторые капсуло- и слизеобразующие бактерии. Но особой устойчивостью обладают споры бактерий. Высушивание под вакуумом из замороженного состояния - лиофилизацию, используют для продления жизнеспособности, консервирования микроорганизмов. Лиофилизированные культуры микроорганизмов и иммунобиологические препараты длительно (в течение нескольких лет) сохраняются, не изменяя своих первоначальных свойств.
Действие излучения. Неионизирующее излучение: ультрафиолетовые и инфракрасные лучи солнечного света, а также ионизирующее излучение - гамма-излучение радиоактивных веществ и электроны высоких энергий губительно действуют на микроорганизмы через короткий промежуток времени. УФ-лучи применяют для обеззараживания воздуха и различных предметов в больницах, родильных домах, микробиологических лабораториях. С этой целью используют бактерицидные лампы УФ-излучения с длиной волны 200-450 нм. Ионизирующее излучение применяют для стерилизации одноразовой пластиковой микробиологической посуды, питательных сред, перевязочных материалов, лекарственных препаратов и др. Однако, имеются бактерии, устойчивые к действию ионизирующих излучений, например, Micrococcus radiodurans была выделена из ядерного реактора.
Действие химических веществ. Химические вещества могут оказывать различное действие на микроорганизмы: служить источниками питания; не оказывать какого-либо влияния; стимулировать или подавлять рост. Химические вещества, уничтожающие микроорганизмы в окружающей среде, называются дезинфицирующими. Процесс уничтожения микроорганизмов в окружающей среде называется дезинфекцией. Антимикробные химические вещества могут обладать бактерицидным, вирулицидным, фунгицидным действием и т.д. Химические вещества, используемые для дезинфекции, относятся к различным группам, среди которых наиболее широко представлены вещества, относящиеся к хлор-, йод- и бромсодержащим соединениям и окислителям. В хлорсодержащих препаратах бактерицидным действием обладает хлор. К этим препаратам относят хлорную известь, хлорамины, пантоцид, неопантоцид, натрия гипохлорит, гипохлорит кальция, дезам, хлордезин, сульфохлорантин и др.
Перспективными антимикробными препаратами на основе йода и брома считаются йодопирин и дибромантин. Интенсивными окислителями являются перекись водорода, калия перманганат и др. Они оказывают выраженное бактерицидное действие. К фенолам и их производным относят фенол, лизол, лизоид, креозот, креолин и гексахлорофен.
Выпускаются также бактерицидные мыла: феноловое, дегтярное, зеленое медицинское - содержит 3.5% гексахлорофена, обладает наилучшими бактерицидными свойствами и рекомендуется для мытья рук сотрудников инфекционных больниц, родильных домов, детских учреждений, предприятий общественного питания и микробиологических лабораторий.
Антимикробным действием обладают также кислоты и их соли (оксолиновая, салициловая, борная); щелочи (аммиак и его соли, бура); спирты (70-80% этанол и др.); альдегиды (формальдегид, р-пропиолактон).
Перспективной группой дезинфицирующих веществ являются поверхностно-активные вещества, относящиеся к четвертичным соединениям и амфолитам, обладающие бактерицидными, моющими свойствами и низкой токсичностью (ниртан, амфолан и др.). Для дезинфекции точных приборов (например, на космических кораблях), а также оборудования и аппаратуры используют газовую смесь из оксида этилена с метилбромидом. Дезинфекцию проводят в герметических условиях.
Влияние биологических факторов. Микроорганизмы находятся друг с другом в различных взаимоотношениях. Совместное существование двух различных организмов называется симбиозом (от греч. simbiosis - совместная жизнь). Различают несколько вариантов полезных взаимоотношений: метабиоз, мутуализм, комменсализм, сателлизм. Метабиоз - взаимоотношение между микроорганизмами, при котором один микроорганизм использует для своей жизнедеятельности продукты жизнедеятельности другого организма.
Метабиоз характерен для почвенных нитрифицирующих бактерий, использующих для метаболизма аммиак, продукт жизнедеятельности аммонифицирующих почвенных бактерий.
Мутуализм - взаимовыгодные взаимоотношения между разными организмами. Примером мутуалистического симбиоза являются лишайники, симбиоз гриба и сине-зеленой водоросли. Получая от клеток водоросли органические вещества, гриб в свою очередь поставляет им минеральные соли и защищает от высыхания.
Комменсализм (от лат. commensalis - сотрапезник) - сожительство особей разных видов, при котором выгоду из симбиоза извлекает один вид, не причиняя другому вреда. Комменсалами являются бактерии, представители нормальной микрофлоры человека.
Сателлизм - усиление роста одного вида микроорганизма под влиянием другого микроорганизма. Например, колонии дрожжей или сарцин, выделяя в питательную среду метаболиты, стимулируют рост вокруг них колоний микроорганизмов. При совместном росте нескольких видов микроорганизмов могут активизироваться их физиологические функции и свойства, что приводит к более быстрому воздействию на субстрат.
Антагонистические взаимоотношения, или антагонистический симбиоз, выражаются в виде неблагоприятного воздействия одного вида микроорганизма на другой, приводящего к повреждению и даже к гибели последнего. Микроорганизмы-антагонисты распространены в почве, воде и организме человека и животных. Хорошо известна антагонистическая активность представителей нормальной микрофлоры толстого кишечника человека - бифидобактерий, лактобацилл, кишечной палочки и др., являющихся антагонистами гнилостной микрофлоры. Механизм антагонистических взаимоотношений разнообразен, распространенной формой антагонизма является образование антибиотиков - специфических продуктов обмена микроорганизмов, подавляющих развитие микроорганизмов других видов. Существуют и другие проявления антагонизма, например, большая скорость размножения, продукция бактериоцинов, в частности колицинов, продукция органических кислот и других продуктов, изменяющих рН среды. Антагонизм может развиваться в форме конкуренции в основном за источники питания: интенсивно развиваясь и истощая питательную среду, микроорганизм-антагонист подавляет рост других микроорганизмов. При хищничестве микроорганизм, например, амеба кишечника, захватывает и переваривает бактерии кишечника. Наконец, такая форма антагонизма, когда микроорганизм использует другой организм как источник питания, называется паразитизмом. Примером паразитизма является взаимоотношение бактериофага и бактерии.
Исследовательская работа "Анализ условий питательной среды для бактерий"
Полезные и опасные, милые и ужасные, смертоносные и дающие жизнь. Они вокруг и их невозможно увидеть. Непросто отыскать более интересный объект для исследований. По количеству невероятных сюжетов мир бактерий можно сравнить с миром привидений. Но в отличие от изучения привидений, из информации о бактериях можно извлечь массу практической пользы, чем научное сообщество и занимается вот уже более ста лет.
Учёные прогнозируют, что результаты изучения жизни бактерий в будущем приведут к:
- открытию секрета долголетия и даже бессмертия (во льдах найдены бактериальные сообщества, в которых обнаружены представители возрастом более миллиона лет);
- получению альтернативных источников энергии, в том числе и пищи;
- получение новых материалов биологического происхождения;
- формированию новых экосистем.
Любое открытие в микробиологии сразу же подхватывается промышленниками, которые внедряют новые технологии в современное производство и предлагают результаты рынку.
Знакомясь с новинками, человек получает возможность не только оперировать более значительным объемом средств в достижении утилитарных целей, но и самостоятельно заглянуть в прошлое планеты Земля и в ее будущее.
Проблема заключается в том, что микроорганизмы распространены повсеместно. Все живые существа - растения, животные и люди - постоянно взаимодействуют с микробами, являясь часто не только их хранилищами, но и распространителями. Ни сверхнизкие температуры Антарктики, ни кипящие струи гейзеров, ни насыщенные растворы солей в соляных бассейнах, ни сильная инсоляция горных вершин, ни резкие колебания кислотности среды, ни многое другое не мешают существованию и развитию микрофлоры в природных субстратах. Взаимодействие человека с бактериальной микрофлорой неизбежно, а его характер зависит от биологической и экологической грамотности человека. Это делает актуальной тему исследования «Анализ условий питательной среды для бактерий».
Цель исследования : изучение условий среды, способствующей росту и размножению бактерий.
Задачи исследования:
1. Получить представление о бактериях и условиях их культивирования;
2. Рассмотреть виды питательных сред для размножения бактерий;
3. Понять особенности размножения бактерий на жидких и плотных питательных средах;
4. Раскрыть влияние факторов окружающей среды на микроорганизмы;
5. Провести бактериологическое исследование.
Объект исследования : бактерии.
Предмет исследования : рост бактерий на различных питательных средах.
Гипотеза : скорость размножения микроорганизмов помимо видовой принадлежности зависит от состава питательной среды, рН, температуры, аэрации и других факторов.
Методы исследования: поисковый метод; наблюдение; анализ, синтез, сравнение; обобщение.
Научная значимость исследования заключается в расширении аппарата для решения заданий ЕГЭ . Практическая значимость исследования состоит в том, что его материалы могут быть использованы в образовательной деятельности по биологии, для проведения занятий в кружке, факультативных занятий.
Обзор литературы
Бактерии и их размножение привлекло внимание учёных со времён Левенгука, когда он впервые увидел их в микроскоп. В 1850-х годах Луи Пастер положил начало изучению физиологии и метаболизма бактерий, а также открыл их болезнетворные свойства. Это послужило возникновению микробиологии - науки, которая
В разное время изучением бактерий занимались Гусев М. В.и Минеева Л. А., Заварзин Г. А., Герхардт Ф. и др. учёные микробиологи.
Рассмотрим наиболее значимые на современном этапе развития микробиологии научные труды, посвящённые питательным для бактерий средам.
К. Френкель в своей монографии «Основы учения о бактериях» [1] подробно охарактеризовал питательные среды, принципы их классификации, требования, предъявляемые к питательным средам, условия культивирования микроорганизмов.
H. В. Прозоркина, П. А. Рубашкина. Свой труд «Основы микробиологии, вирусологии и иммунологии» посвятили описанию методов микробиологических исследований [2] . Эти труды и послужили методологической основой для нашего исследования.
1. Питательные среды для размножения бактерий: условия, виды
1.1. Бактерии и условия их культивирования
1.Размножение бактерий на жидких и плотных питательных средах
Бактерии, как правило, характеризуются высокой скоростью размножения по сравнению с другими прокариотами. Скорость их размножения, помимо видовой принадлежности, зависит от состава питательной среды, рН, температуры, аэрации и других факторов. На плотных питательных средах бактерии образуют скопления клеток, называемые колониями. Внешний вид колоний у многих бактерий настолько характерен, что может служить одним из дифференциальных признаков для их идентификации. Колонии разных видов отличаются по своим размерам, форме, поверхности, окраске, прозрачности и др. Однако эти признаки могут изменяться в зависимости от условий культивирования.
На жидких средах рост бактерий характеризуется образованием пленки на поверхности питательной среды, равномерного помутнения, либо осадка.
Размножение бактерий определяется временем генерации, т. е. периодом, в течение которого осуществляется деление клетки. Продолжительность генерации зависит от вида бактерий, возраста, популяции, состава питательной среды, температуры и других факторов. В оптимальных условиях время генерации у разных бактерий колеблется довольно в широких пределах: от 20 минут у кишечной палочки до 14 ч у мик о бактерий туберкулеза, в связи с чем их колонии образуются через 18 - 20 ч либо через 3 - 5 недели соответственно [3] .
При выращивании бактерий в жидкой питательной среде наблюдается последовательная смена отдельных фаз в развитии популяции, отражающая общую закономерность роста и размножения бактериальных клеток.
Динамика развития бактериальной популяции представлена на рис.1

Рис.1. Динамика развития бактериальной популяции
I - исходная стационарная фаза начинается после внесения бактерий в питательную среду. В течение данной фазы число бактериальных клеток не увеличивается.
II - лаг-фаза , или фаза задержки размножения, характеризуется началом интенсивного роста клеток, но скорость их деления остается невысокой. Две первые фазы можно назвать периодом адаптации бактериальной популяции, продолжительность которого определяется возрастом культуры, а также количеством и качеством питательной среды.
III - лог-фаза , или логарифмическая (экспоненциальная), фаза отличается максимальной скоростью размножения клеток и увеличением численности бактериальной популяции в геометрической прогрессии. Логарифмическая фаза у бактерий с коротким временем генерации продолжается несколько часов.
IV - фаза отрицательного ускорения характеризуется меньшей активностью бактериальных клеток и удлинением периода генерации. Это происходит в результате истощения питательной среды, накопления в ней продуктов метаболизма и дефицита кислорода.
1.2.Принципы культивирования бактерий
Микроорганизмы культивируют, как правило, на искусственных питательных средах. В зависимости от пищевых потребностей того или другого вида питательные среды должны содержать соответствующие исходные вещества, необходимые для пластического и энергетического метаболизма.
Выделение микроорганизмов из различных материалов и получение их культур широко используется в лабораторной практике для микробиологической диагностики инфекционных заболеваний, в научно-исследовательской работе и в микробиологическом производстве вакцин, антибиотиков и других биологически активных продуктов микробной жизнедеятельности. [4]
Условия культивирования также зависят от свойств соответствующих микроорганизмов. Большинство патогенных микробов выращивают на питательных средах при температуре 37 °С в течение 1-2 сут. Однако некоторые из них нуждаются в более длительных сроках. Например, бактерии коклюша - в 2-3 сут, а микобактерии туберкулеза - в 3-4 нед.
Для стимуляции процессов роста и размножения аэробных микробов, а также сокращения сроков их выращивания используют метод глубинного культивирования, который заключается в непрерывном аэрировании и перемешивании питательной среды. Глубинный метод нашел широкое применение в биотехнологии.
Требования к питательным средам . Для выращивания бактерий в лабораторных условиях, исследования их разнообразных свойств, длительного хранения используют питательные среды. Они должны отвечать определенным стандартам, создавая оптимальные условия для роста, размножения и жизнедеятельности микроорганизмов.
В первую очередь, бактерии нуждаются в азоте, углероде и водороде для построения собственных белков. Водород и кислород для клеток поставляет вода. Источником азота выступают многочисленные вещества, в основном, животного происхождения (мясо говяжье, рыба, мясо-костная мука, казеин. Можно использовать и заменители мяса - плаценту, кровяные сгустки, дрожжи. Следовательно, в состав сред должны быть введены источники питательных веществ и вода, а также ростовые факторы (витамины группы В, ферменты). Универсальным источником их служат экстракты из белков животного и растительного происхождения. Для микробов с более сложными пищевыми потребностями в состав сред включают субстраты - кровь, сыворотку, яичный желток, кусочки печенки, почек, мозговой ткани и др. [5]
Среды должны быть сбалансированными за микроэлементным составом и содержать ионы железа, меди, марганца, цинка, кальция, натрия, калию, иметь в своем составе неорганические фосфаты.
Среды должны иметь определенную вязкость, плотность, иметь определенную влажность (до 20 % воды), быть прозрачными и обязательно стерильными.
Oсновные требования к питательным средам: прозрачность; стерильность; лёгкая усвояемость; определенный состав азотистых веществ, углеводов, витаминов; определённая вязкость.
1. 3. Основные питательные среды.
Многочисленные потребности микроорганизмов предопределяют большое разнообразие питательных сред, а для отдельных видов бактерий существуют специальные среды. Часть их готовят в лабораториях непосредственно перед посевом, но с каждым годом появляются все новые и новые среды заводского изготовления (сухие), которые способны удовлетворить самые прихотливые потребности микробиологов. Они сохраняются длительное время, имеют стандартный состав.
Среды разделяются на естественные и искусственные. Для создания естественных сред используют свернутую сыворотку, молоко, яйца, мышечную ткань.
Искусственные среды создают путем комбинирования разнообразных субстратов, которые обеспечивают те или другие потребности микроорганизмов. Их используют в основном для экспериментального изучения отдельных звеньев метаболизма бактерий.
В зависимости от своей плотности, среды разделяются на жидкие, полужидкие и плотные. Полужидкие и плотные среды готовятся из жидких, добавляя соответственно 0,3-0,7 % но 1,5-2,0 % агара. Последний представляет собой волокнистый материал, который добывают из морских водорослей. Состоит он из полисахаридов (70-75 %), белков (2-3 %). Для создания плотных сред используют также желатин (10-15 %), свернутую сыворотку крови.
В зависимости от потребностей бактериологов питательные среды разделяются на пять основных групп (прил.1 таблица 1) .
Первая группа - универсальные (простые) среды. К ним принадлежат мясо-пептонний бульон (МПБ) и мясо-пептоннийагар (МПА). За своим составом, наличием питательных веществ они пригодны для культивирования многих видов бактерий.
Вторая группа - специальные среды. Они используются в тех случаях, когда микроорганизмы не растут на простых. К ним принадлежит кровяной, сывороточный агары, сывороточный бульйон, асцитический бульйон, асцит-агар и другие.
Третья группа - элективные среды, на которых микроорганизмы определенного вида растут быстрее, более интенсивно, опережают в своем развитии другие виды бактерий.
Четвертая группа селективные среды, которые благодаря добавлению определенных компонентов (желчь, краски, антибиотики и др.) способны подавлять развитие одних видов микроорганизмов, но не влияют на другие виды.
Пятая группа - дифференциально-диагностичнеские среды. Это большая группа сред, которые позволяют определить определенные биохимические свойства микроорганизмов и проводить их дифференциацию.

Рис.2.Среда Плоскирева. Рис.3. Среда Левина
2.Влияние окружающей среды на микроорганизмы
Рассмотрим факторы окружающей среды, влияющие на микроорганизмы.
Температура. Низкие температуры бактерии выдерживают сравнительно легко. Культуры микроорганизмов в замороженном виде сохраняются в лабораторных условиях более чем 80 лет. Выделено жизнеспособный микроорганизм из толщи ледников, возраст которых 12 000 лет.
Холерный вибрион не погибает при температуре -32 °С; некоторые виды бактерий хранят жизнеспособность при температуре жидкого воздуха ( -190 °С), жидкого водорода (-253 °С).
Низкие температуры прекращают процессы гниения и брожения. На этом принципе основывается использование в практике ледников, погребов и холодильных установок для хранения пищевых продуктов.
Пагубно действуют на бактерии высокие температуры. Большинство бактерий погибают при температуре 58-60 °С через 30-60 мин, при 100 °С - в течение 2-3 мин. Силикатные бактерии сохраняются жизнеспособными после деяния на них нагревание до 160 °С.
Высушивание . Стойкость микроорганизмов к высушиванию разная. Чувствительные к высушиванию гонококки, менингококки, трепонемы, лептоспиры, гемофильные бактерии, фаги. Холерный вибрион не погибает под воздействием высушивания 2 сутки, шигели- 7, чумная палочка - 8, дифтерийная -30, брюшнотифозная - 70, стафилококки и микобактерии туберкулеза - 90 суток. Высохшая мокрота больных туберкулезом остается заразной 10 месяцев, споры бацилл сибирской язвы сохраняются до 10 годов, плесневых грибов - 20 лет.
Лучевая энергия . Разные виды излучения имеют бактерицидное или стерилизующее действие. К ней принадлежат ультрафиолетовое, рентгеновское, альфа-, бета-, гамма- и нейтронное излучение. Наиболее выраженное бактерицидное действие имеет прямой солнечный луч.
Высокое давление, ультразвук, механическое сотрясение . Воздействие высокого атмосферного давления 10 132,5 - 91 192,5 кПа (100-900 атм) на глубине морей и океанов 1000-10 000 м бактерии переносят легко. Дрожжи хранят свою жизнеспособность при давлению 50 662,5 кПа (500 атм). Некоторые бактерии, дрожжи, плесневые грибы выдерживают давление 303 975 кПа (3000 атм), фитопатогенные вирусы - 506 625 кПа (5000 атм).
Ультразвук имеет бактерицидные свойства, которые используют для стерилизации пищевых продуктов, изготовления вакцин и дезинфекции предметов.
3. Проведение бактериологического исследования
3.1 Организация проведения бактериологического исследования
Внешняя среда микроорганизмов
Влажность
Микроорганизмы могут жить и развиваться только в среде с определенным содержанием влаги. Вода необходима для всех процессов обмена веществ микроорганизмов, для нормального осмотического давления в микробной клетке, для сохранения ее жизнеспособности. У различных микроорганизмов потребность в воде не одинакова. Бактерии относятся в основном к влаголюбивым, при влажности среды ниже 20 % их рост прекращается. Для плесеней нижний предел влажности среды составляет 15%, а при значительной влажности воздуха и ниже. Оседание водяных паров из воздуха на поверхность продукта способствует размножению микроорганизмов.
При снижении содержания воды в среде рост микроорганизмов замедляется и может совсем прекращаться. Поэтому сухие продукты могут храниться значительно дольше продуктов с высокой влажностью. Сушка продуктов позволяет сохранять продукты при комнатной температуре без охлаждения.
Температура
Температура — важнейший фактор для развития микроорганизмов. Для каждого из микроорганизмов существует минимум, оптимум и максимум температурного режима для роста. По этому свойству микробы подразделяются на три группы:
- психрофилы — микроорганизмы, хорошо растущие при низких температурах с минимумом при -10-0 °С, оптимумом при 10-15 °С;
- мезофилы — микроорганизмы, для которых оптимум роста наблюдается при 25-35 °С, минимум — при 5-10 °С, максимум — при 50-60 °С;
- термофилы — микроорганизмы, хорошо растущие при относительно высоких температурах с оптимумом роста при 50-65 °С, максимумом — при температуре более 70 °С.
Низкие температуры замедляют рост микроорганизмов, но не убивают их. В охлажденных пищевых продуктах рост микроорганизмов замедленно, но продолжается. При температуре ниже О °С большинство микробов прекращают размножаться, т.е. при замораживании продуктов рост микробов останавливается, некоторые из них постепенно отмирают. Установлено, что при температуре ниже О °С большинство микроорганизмов впадают в состояние, похожее на анабиоз, сохраняют свою жизнеспособность и при повышении температуры продолжают свое развитие. Это свойство микроорганизмов следует учитывать при хранении и дальнейшей кулинарной обработке пищевых продуктов. Например, в замороженном мясе могут длительно сохраняться сальмонеллы, а после размораживания мяса они в благоприятных условиях быстро накапливаются до опасного для человека количества.
При воздействии высокой температуры, превышающей максимум выносливости микроорганизмов, происходит их отмирание. Бактерии, не обладающие способностью образовывать споры, погибают при нагревании во влажной среде до 60-70 °С через 15-30 мин, до 80-100 °С — через несколько секунд или минут. У спор бактерий термоустойчивость значительно выше. Они способны выдерживать 100 °С в течение 1-6 ч, при температуре 120-130 °С споры бактерий во влажной среде погибают через 20-30 мин. Споры плесеней менее термостойки.
Тепловая кулинарная обработка пищевых продуктов в общественном питании, пастеризация и стерилизация продуктов в пищевой промышленности приводят к частичной или полной (стерилизация) гибели вегетативных клеток микроорганизмов.
Низкая пастеризация проводится при температуре, не превышающей 65-80 °С, не менее 20 мин для большей гарантии безопасности продукта.
Стерилизация предусматривает освобождение продукта от всех форм микроорганизмов, в том числе и спор. Стерилизация баночных консервов проводится в специальных устройствах — автоклавах (под давлением пара) при температуре 110-125°С в течение 20-60 мин. Стерилизация обеспечивает возможность длительного хранения консервов. Молоко стерилизуется метолом ультравысокотемпературной обработки (при температуре выше 130 °С) в течение нескольких секунд, что позволяет сохранить все полезные свойства молока.
Реакция среды
Жизнедеятельность микроорганизмов зависит от концентрации водородных (Н + ) или гидроксильных (ОН - ) ионов в субстрате, на котором они развиваются. Для большинства бактерий наиболее благоприятна нейтральная (рН около 7) или слабощелочная среда. Плесневые грибы и дрожжи хорошо растут при слабокислой реакции среды. Высокая кислотность среды (рН ниже 4,0) препятствует развитию бактерий, однако плесени могут продолжать расти и в более кислой среде. Подавление роста гнилостных микроорганизмов при подкислении среды имеет практическое применение. Добавление уксусной кислоты используется при мариновании продуктов, что препятствует процессам гниения и позволяет сохранить продукты. Образующаяся при квашении молочная кислота также подавляет рост гнилостных бактерий.
Концентрация соли и сахара
Поваренная соль и сахар издавна используются для повышения стойкости продуктов к микробной порче и лучшей сохранности пищевых продуктов.
Повышение содержания растворенных веществ (соли или сахара) в питательной среде сказывается на величине осмотического давления внутри микроорганизмов, вызывает их обезвоживание. При повышении концентрации поваренной соли в субстрате более 3-4 % размножение многих, в том числе гнилостных, микроорганизмов замедляется, при концентрации более 7-12% — прекращается.
Некоторые микроорганизмы нуждаются для своего развития в высоких концентрациях соли (20 % и выше). Их называют солелюбивыми, или галофилами. Они могут вызывать порчу соленых продуктов.
Высокие концентрации сахара (выше 55-65 %) прекращают размножение большинства микроорганизмов, это используется при приготовлении из плодов и ягод варенья, джема или повидла. Однако эти продукты тоже могут подвергаться порче в результате размножения осмофильных плесеней или дрожжей.
Некоторым микроорганизмам свет необходим для нормального развития, но для большинства из них он губителен. Ультрафиолетовые лучи солнца обладают бактерицидным действием, т. е. при определенных дозах облучения приводят к гибели микроорганизмов. Бактерицидные свойства ультрафиолетовых лучей ртутно-кварцевых ламп используют для дезинфекции воздуха, воды, некоторых пищевых продуктов. Инфракрасные лучи тоже могут вызвать гибель микробов за счет теплового воздействия. Воздействие этих лучей применяют при тепловой обработке продуктов. Негативное воздействие на микроорганизмы могут оказывать электромагнитные поля, ионизирующие излучения и другие физические факторы среды.
Химические факторы
Некоторые химические вещества способны оказывать на микроорганизмы губительное действие. Химические вещества, обладающие бактерицидным действием, называют антисептиками. К ним относятся дезинфицирующие средства (хлорная известь, гипохлориты и др.), используемые в медицине, на предприятиях пищевой промышленности и общественного питания.
Биологические факторы
Между различными микроорганизмами могут устанавливаться разные взаимоотношения: симбиоз- взаимовыгодные отношения; метабиоз — жизнедеятельность одного за счет другого без принесения вреда; паразитизм — жизнедеятельность одного за счет другого с причинением ему вреда; антагонизм — один из видов микроорганизмов угнетает развитие другого, что может привести к гибели микробов. Например, развитие молочнокислых бактерий угнетает рост гнилостных, эти антагонистические взаимоотношения используют при квашении овощей или для поддержания нормальной микрофлоры в кишечнике человека.
Антагонистические свойства некоторых микроорганизмов объясняются способностью их выделять в окружающую среду вещества, обладающие антимикробным (бактериостатическим, бактерицидным или фунгицидным) действием, — антибиотики. Антибиотики продуцируются в основном грибами, реже бактериями, они оказывают свое специфическое действие на определенные виды бактерий или грибов (фунгицидное действие). Антибиотики применяются в медицине (пенициллин, левомицетин, стрептомицин и др.), в животноводстве в качестве кормовой добавки, в пищевой промышленности для консервирования пищевых продуктов (низин).
Читайте также:
